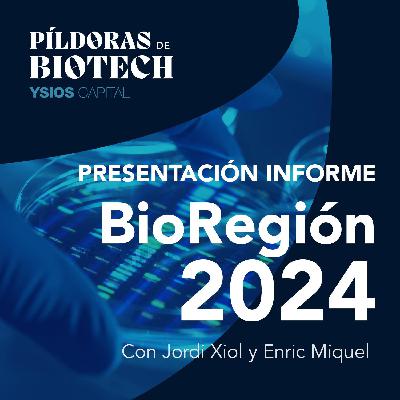

Discover
PÍLDORAS de BIOTECH
PÍLDORAS de BIOTECH
Author: Ysios Capital & Pharma New Talent
Subscribed: 5Played: 18Subscribe
Share
© 2024
Description
PÍLDORAS de BIOTECH es un podcast conducido por Jordi Xiol y Enric Miquel. Un espacio de divulgación científica dentro del ámbito Farma y Biotech. Con el respaldo de Ysios Capital, un fondo de capital riesgo que invierte en la medicina del futuro desde 2009, esta producción ofrece análisis sobre innovaciones terapéuticas, descubrimientos científicos y acuerdos estratégicos clave en la industria.
18 Episodes
Reverse
Arrancamos 2026 haciendo zoom sobre una de las grandes palancas del sector Biotech: fusiones y adquisiciones (M&A). El 2025 fue un año récord con más de 200.000 millones de dólares invertidos por Big Pharma en operaciones estratégicas.
Repasamos la adquisición de Sidara por Merck: "una vacuna pero que no es una vacuna".
Terapias In Vivo CAR-T: Una tendencia emergente que transforma la terapia celular. Compañías como Capstan Therapeutics (AbbVie), ESO Biotech (AstraZeneca) e Interius Biotherapeutics (Gilead) marcan el paso hacia tratamientos menos invasivos y más escalables.
Además, contamos con un invitado de lujo: Joan Perelló, fundador y ex-CEO de Sanifit, empresa adquirida por Vifor tras más de una década de relación.
Joan nos comparte:
• El "Fire-Deal"con GSK por dentro
• Lecciones clave sobre de-risking
• Dual track (IPO vs M&A)
• Cómo “las compañías se compran, no se venden”.
Una masterclass comprimida sobre cómo se construyen compañías para ser atractivas cuando la farma "sale de compras".
Minutaje del Episodio:
[00:00]: 2025, el año récord del M&A (+200.000 M $).
[02:30]: Merck compra Sidara. ¿El fin de la vacuna de la gripe tradicional?
[06:00]: Fiebre por el In Vivo CAR-T. AbbVie, AstraZeneca y Gilead sacan la chequera.
[09:00]: Joan Perelló y el origen de Sanifit en el Parc Bit (Mallorca),.
[12:30]: Lecciones de crisis, el acuerdo con GSK en 2012
[18:00]: Filosofía de venta: De-risking
[21:00]: Estrategia Dual Track (IPO vs M&A) .
[25:00]: El proceso final y la oferta
[28:00]: Venture Capital y Referral Checks con Pharma
[33:00]: ¿Qué hay después de cumplir el sueño Biotech?
SPONSOR:
👉 https://ysioscapital.com/ Invirtiendo en la medicina del futuro desde 2008 💸🧪🔬
En este episodio especial de cierre de año, hacemos un repaso de los grandes temas que han marcado el sector Biotech y Pharma en 2025: inversión, geopolítica, avances clínicos y acuerdos estratégicos que anticipan lo que vendrá en 2026.
Minutaje del episodio:
[01:00]: Rewind 2025: el año del regreso de la Biotech.
[02:30]: El auge del M&A en 2025
[04:40]: El apetito inversor por la obesidad, la puja de Novo y Pfizer por Metsera.
[06:40]: Narcolepsia y orexina: Takeda, Centessa y avances clínicos.
[13:40]: Estados Unidos: política, vacunas y precios en la era Trump.
[21:20]: Malaria: Novartis y un nuevo gold standard para la enfermedad olvidada.
[26:40]: Wrapped 2025 de Ysios Capital: rondas, fondos y acuerdos.
[29:20]: Mirando a 2026: tendencias y fuentes para seguir el sector biotech.
SPONSOR: 👉
https://ysioscapital.com/ Invirtiendo en la medicina del futuro desde 2008 💸🧪🔬
Desde el Vall d’Hebron Research Institute (VHIR), un pequeño grupo de investigadores ha logrado algo extraordinario: que la FDA apruebe un nuevo tratamiento para una enfermedad mitocondrial ultra rara: el déficit de timidina quinasa 2.
Hablamos de una terapia que reduce la mortalidad en un 86% y que ha llegado al mercado tras una colaboración transatlántica entre Barcelona, Columbia University y una biotech en California, creada ad hoc para llevarla adelante.
Con el Dr.Ramon Martí como invitado especial, profundizamos en el origen de esta terapia, su impacto transformador para los pacientes y en cómo una historia de uso compasivo, decisión clínica y química se ha convertido en un caso de éxito internacional.
Una historia que empieza en un laboratorio de Barcelona, cruza el Atlántico dos veces… y termina salvando vidas en todo el mundo.
Minutaje episodio:
[00:28]: Vall d’Hebron y un nuevo hito en enfermedades raras.
[01:11]: Reducir la mortalidad en un 86%.
[01:26]: De Columbia(NY) a Barcelona, pasando por California.
[01:44]: Special guest: Dr.Ramon Martí, VHIR.
[02:14]: ¿Qué es el déficit de TK2d?una nueva aproximación terapéutica.
[03:36]: De la investigación básica al uso compasivo en pacientes.
[04:20]: Timidina y desoxicitidina, bases de un tratamiento efectivo.
[06:32]: Ultra rara, letal y sin opciones terapéuticas.
[09:17]: Primeros resultados clínicos.
[15:41]: La Biotech entra en escena: creación de Modis Therapeutics.
[17:00]: El papel del inversor.
[18:46]: Modis Therapeutics, Zogenix y UCB.
[19:22]: El viaje desde la academia: retos y aprendizajes.
[21:00]: ¿Por qué la FDA aprobó antes que la EMA?.
[23:20]: Un tratamiento que salvará vidas.
[25:03]: Reflexiones sobre el ecosistema ¿cómo seguimos?.
[27:32]: Regulación, tech transfer y visión.
SPONSOR:
👉 https://ysioscapital.com/
Invirtiendo en la medicina del futuro desde 2008 💸🧪🔬
Desde Barcelona, un fármaco nacido en el laboratorio de Eduard Batlle en el IRB ha desencadenado uno de los mayores deals del año en el sector biotech.
Genmab adquiere la compañía holandesa Merus por 8.000 M$ para hacerse con Petosentamab, un anticuerpo biespecífico con resultados prometedores en oncología.
Hablamos del origen español de este avance terapéutico, de cómo organoides y células madre tumorales han permitido descubrir una diana relevante, y de por qué esta historia es un caso ejemplar de colaboración academia–industria que ha cruzado fronteras.
Minutaje episodio:
[00:00]: Nuevo hito biotech local para 2025.
[00:33]: Genmab adquiere Merus por 8.000M$: ¿qué hay detrás de esta operación?.
[01:01]: Petosentamab, un anticuerpo oncológico nacido en el IRB.
[02:04]: Perspectiva de mercado y proyecciones.
[03:41]: De la academia a la industria.
[05:02]: Organoides y células madre tumorales: claves del laboratorio de Batlle
[06:03]: A vueltas con los anticuerpos biespecífico.
[08:18]: Resultados clínicos en cáncer de cabeza y cuello. (60%)
[10:14]: Decepción en cáncer de colon, ¿prometedor en otras áreas?
[14:03]: ¿Qué significa esto para la biotecnología española?
[15:13]: Petosentamab, el 3er fármaco oncológico español con potencial real.
[16:45]: Celebremos, comuniquemos y hagamos visible la ciencia hecha aquí.
SPONSOR:
👉 https://ysioscapital.com/
Invirtiendo en la medicina del futuro desde 2008 💸🧪🔬
Desde Francia, Abivax, una biotech hasta ahora "pequeñita", irrumpe en el radar internacional con datos clínicos positivos en colitis ulcerosa y se cuela de golpe en el club del Big Biotech europeo. Su molécula, Obefazimod, administrada por vía oral y con un origen fortuito, ha demostrado un beneficio clínico claro en dos ensayos fase 3, sorprendiendo a toda la comunidad.
Además del potencial terapéutico, nos detenemos en la figura de su CEO, Marc de Garidel, y en su historial de éxitos, que empieza a recordar al de los grandes fundadores del sector.
¿Estamos ante una futura adquisición por parte de una big pharma? ¿Es este solo el comienzo de una plataforma más amplia?
Y aprovechamos para explorar cómo la serendipia, desde Fleming hasta la talidomida, sigue desempeñando un papel fundamental en los avances terapéuticos, incluso en plena era de la medicina racional.
Minutaje del Episodio:
[00:00]: Bienvenida, post-vacacional con noticia bomba
[00:32]: ¿Quién es Abivax? Historia de una biotech desconocida
[01:25]: Obefazimod y colitis ulcerosa: contexto clínico
[03:07]: Una enfermedad crónica, grave y con pocas opciones curativas
[04:49]: ¿Qué ha pasado en los ensayos de fase 3?
[07:00]: Por qué el mercado no lo vio venir: expectativa cero
[08:41]: Datos clínicos: +20% de remisión vs. placebo, y lo que se espera a 52 semanas
[10:03]: Obefazimod: oral, buen perfil de seguridad y potencial disruptivo
[12:25]: El origen serendípico del fármaco: de VIH a colitis
[14:30]: ¿Cómo se decide probar un compuesto así en IBD?
[16:15]: ¿Puede funcionar también en Crohn y más allá?
[19:04]: CEO Marc de Garidel: tres exits consecutivos y ahora esto
[21:50]: ¿Adquisición a la vista? ¿IPO en EE. UU.?
[23:26]: Serendipia en farma: el caso de la talidomida y la degradación de proteínas
[26:34]: ¿Nuevo campo terapéutico por descubrir con Obefazimod?
[27:50]: Cierre y reflexión: azar, intuición y ciencia
SPONSOR:
👉 https://ysioscapital.com/
Invirtiendo en la medicina del futuro desde 2008 💸🧪🔬
En este episodio abrimos con un recuerdo y homenaje a Raúl Martín Ruiz, socio de Ysios Capital y figura clave en el nacimiento del ecosistema biotech español.
Este mes de julio ampliamos el foco (tras analizar la mayor ronda biotech de la historia en España: SpliceBio 119 M €) para repasar el state of the art europeo: desde el impacto del acuerdo de licencia de BioNTech, hasta cómo se compara Europa con EE. UU. y China en innovación, capitalización bursátil y número de ensayos clínicos.
Repasamos el mapa del Big 5 europeo (Argenx, BioNTech, Genmab, Ascendis y Verona Pharma) y lo contrastamos con el ecosistema estadounidense, donde hay más de 25 compañías por encima de los 5.000 M € de capitalización.
Y por supuesto, abordamos la gran batalla en obesidad entre Novo Nordisk y Eli Lilly, la evolución de las grandes farma europeas como AstraZeneca, Roche o Novartis, y la gran pregunta: ¿está Europa reaccionando a tiempo o se está quedando atrás?
Minutaje del Episodio:
[00:00]: In memoriam, homenaje a Raúl Martín Ruiz
[01:31]: Zoom out desde Splice Bio al panorama europeo
[02:24]: El megadeal de BioNTech y BMS -11.500 M$
[04:41]: ¿Nuevo golden age para el bioteh europeo?
[06:06]: Biontech vs. Moderna: caminos divergentes tras la pandemia
[10:13]: Big 5 europeo: Argenx, BioNTech, Genmab, Ascendis, Verona Pharma
[13:19]: Comparativa directa, Europa vs EEUU
[17:12]: Obesidad, sigue la batalla Novo Nordisk vs Eli Lilly
[21:07]: ¿Estamos perdiendo el tren de la innovación desde Europa?
[24:00]: ¿Ensayos clínicos hacia el farolillo rojo?
[25:26]: Novartis y Roche, cada vez más americanizadas
SPONSOR:
👉 https://ysioscapital.com/
Invirtiendo en la medicina del futuro desde 2008 💸🧪🔬
En este episodio documentamos desde dentro, con Miquel Vila i Perelló, CEO de Splice Bio y Jordi Xiol, Partner de Ysios Capital y Consejero en Splice Bio, la mayor ronda de financiación de una Biotech de la historia en España, una serie B de 135 millones de dólares (119 M €).
¿Cómo un científico dedicado a la investigación básica termina cofundando una Biotech?
Saltar el charco para ir a Nueva York, acceder a un posdoc en Rockefeller, luego a Princeton para terminar volviendo a Barcelona y concretar con su cofundadora, Silvia Frutos una nueva aventura empresarial.
Aprendizajes, retos y planes de futuro, todo dentro de este podcast.
Minutaje del Episodio:
[00:00]: Episodio para la historia de Píldoras de Biotech
[02:01]: Behind de Scenes en una serie B de 119M€ (135M$)
[03:37]: Orígenes de SpliceBio
[06:06]: Rebranding y pasar de 4 a 40 personas
[08:09]: Aprender yendo en bici
[09:02]: Serie B de 119 M €, ¿Por qué ahora?
[12:30]: Enero 2025, SpliceBio trata a su primer paciente
[14:03]: Stargardt, perder la vista poco a poco
[18:16]: Inteínas, tecnología diferencial
[20:33]: Una inyección una vez en la vida para evitar la ceguera
[22:30]: Retos para demostrar eficacia y durabilidad
[24:50]: 2 maletas y 1 camisa, velcro molecular
[26:03]: China y la velocidad de ejecución
[29:06]: ¿Cómo imaginas una serie C?
[30:50]: Atracción de talento y perfil inversor, ventaja competitiva
SPONSOR:
👉 https://ysioscapital.com/
Invirtiendo en la medicina del futuro desde 2008 💸🧪🔬
La edición del ADN ya no es ciencia ficción. En este episodio analizamos un avance histórico: los primeros datos clínicos de Beam Therapeutics, que demuestran la corrección de una mutación genética causante de enfermedad en pacientes humanos.
Desde las bases moleculares del CRISPR hasta sus implicaciones clínicas y éticas, exploramos el impacto real de “reescribir el libro de la vida”. También hablamos del lobo huargo, de baby design , xenotrasplantes y hasta de Elon Musk.
Minutaje del episodio:
[0:15]: ADN como el libro de la vida.
[3:12]: Beam Therapeutics: edición genética directa en pacientes con enfermedad rara.
[5:54]: CRISPR explicado para dummies.
[8:15]: Deficiencia de α-1 antitripsina y edición precisa
[10:03]: Un nucleótido para corregir una enfermedad: ¿el inicio de una nueva era?
[11:04]: CRISPR Therapeutics y Casgevy: ¿misma tecnología, diferentes caminos?
[13:22]: Obstáculos comerciales y complejidad de la terapia celular.
[16:35]: He Jiankui y las gemelas inmunes al VIH, la frontera ética.
[20:48]: Elon Musk, Twitter (X) y rumores CRISPR.
[21:13]: ¿Lobo huargo resucitado? Deextinción genética y titulares virales.
[23:30]: Xenotrasplantes: órganos de cerdo para humanos.
SPONSOR:
👉 https://ysioscapital.com/
Invirtiendo en la medicina del futuro desde 2008 💸🧪🔬
El momento Sputnik 1957 (o DeepSeek si quieres un ejemplo reciente) para Biotech llegó con el ensayo clínico que sorprendió al mundo, en el que un fármaco chino (Ivonescimab) superó a Keytruda, líder mundial en oncología.
La oferta de la Biotech China, va mucho más allá del "Me too: Generics & Manufacturing". Ahora se desarrollan fármacos Best In Class, por una fracción del coste que lo harían en EEUU o Europa.
En este episodio exploramos por qué China se está convirtiendo en un foco global de innovación farmacéutica.
Minutaje episodio:
[0:15]: "Sputnik moment" en Biotech: China bate a Keytruda.
[3:16]: Facts and Figures para dimensionar el mercado chino.
[4:30]: +25% de ensayos clínicos globales son ya chinos.
[5:06]: Boom de licencias farmacéuticas con China: más de 80 sólo en 2023.
[5:58]: Caso Carvykti: cambio de paradigma en terapia celular.
[8:24]: La Big Pharma Occidental pone sus ojos en China.
[9:08]: Tres claves del auge chino: regulación, talento y capital.
[11:00]: Regulación en China: de 501 días a 87 para iniciar ensayos.
[12:34]: El Retorno "Tortugas Marinas".
[15:20]: El rol del capital riesgo en el crecimiento de biotechs chinas.
[19:56]: Más allá de oncología: obesidad, inmunología e inflamación.
[20:12]: ¿Cómo puede Europa competir con el avance biotech de China?
[22:20]: Incertidumbre geopolítica: ¿riesgo o oportunidad para la colaboración con China?
[25:59]: El reto a la audiencia de PÍLDORAS de BIOTECH.
SPONSOR:
👉 https://ysioscapital.com/
Invirtiendo en la medicina del futuro desde 2008 💸🧪🔬
Día 17 de febrero de 2025 se presentó el Informe BioRegión 2024, un documento clave para entender la evolución del ecosistema biotecnológico local. Se recogen los principales indicadores de innovación y los datos macroeconómicos del sector Life-Sciences en Cataluña actualizados hasta diciembre de 2024, incluyendo las cifras de inversión.
Este episodio de PÍLDORAS de BIOTECH, explora los highlights.
Minutaje episodio:
[0:15]: Talento en Competitive Intelligence y Venture Capital.
[2:15]: Ecosistema Biotech local: Informe BioRegión.
[5:16]: Cifras clave de inversión en 2024: 347M€ invertidos en scale-ups y startups. Ronda de 110M€ de Impress.
[6:12]: 80% de la inversión de la BioRegión proveniente del Venture Capital.
[10:17]: De 50 en el año 2000 a casi 1.000 en 2023.
[15:02]: Liderazgo de Ensayos clínicos en la UE, con Barcelona como epicentro.
[14:28]: AstraZeneca y su apuesta: 1.500 empleos en su hub de investigación en Barcelona.
[22:25]: Tendencias y futuro del sector Biotech.
Enlaces de interés:
Informe completo BIORREGIÓN 2024: https://informe.biocat.cat/
Entradas Medical Device Night (13/03): https://www.eventbrite.es/e/entradas-medical-device-night-1148577188289
SPONSOR:
👉 https://ysioscapital.com/
Invirtiendo en la medicina del futuro desde 2008 💸🧪🔬
Comenzamos el año con un análisis profundo de uno de los eventos más importantes del calendario pharma y biotech: la Healthcare Conference de J.P. Morgan en San Francisco. Este evento reúne a líderes globales de la industria, inversores y equipos directivos para trazar el camino del sector en el nuevo año.
En este episodio, desglosamos los highlights del evento y comparten su visión sobre los acuerdos más relevantes, las tendencias clave y los retos que marcarán el 2025.
¿Qué encontrarás en este episodio?
[1:09]: JP Morgan Healthcare Conference: la conferencia más exclusiva de la industria.
[3:12]: Impacto global: adquisiciones y licencias que definen 2025.
[12:00]: Eli Lilly, Johnson & Johnson y GSK toman la delantera.
[17:04]: Scorpion Therapeutics: oncología y la expansión de Eli Lilly.
[18:43]: Intracellular Therapies y su apuesta por la Salud Mental via Johnson & Johnson.
[19:45]: GSK e IDRx: innovación en tumores gastrointestinales.
[6:47]: La seguridad en eventos: asesinato del CEO de United Healthcare.
[22:49]: Política y sector salud: congelación del NIH y su impacto en la investigación biomédica.
Un episodio imperdible que analiza el papel de las grandes farmacéuticas, los movimientos de inversión y las tendencias que darán forma al futuro de la industria.
SPONSOR:
👉 https://ysioscapital.com/
Invirtiendo en la medicina del futuro desde 2008 💸🧪🔬
Cerramos el año con un especial Navidad de Píldoras de Biotech que repasa los hitos más importantes de 2024. Desde avances clínicos, nuevos lanzamientos y hasta polémicas corporativas. Analizamos los eventos que han dado forma a la industria este año y proyectamos qué esperar en 2025.
Temas tratados:
[01:12]: 6 meses de Píldoras de Biotech y Highlights del año.
[02:23]: Scholar Rock, Apitegromab e inhibición de Miostatina: avances en Atrofia Muscular Espinal (AME).
[09:01]: Cobenfy, agua en el desierto terapéutico de la esquizofrenia.
[12:26]: Pfizer en crisis: polémicas, activismo inversor y bolsa en valores de los 90.
[18:24]: Obesidad 2.0: nuevos horizontes para los agonistas GLP-1.
[20:06]: Terapias oncológicas aplicadas a enfermedades autoinmunes.
[22:08]: Lo que traerá 2025: +IA, Geopolítica y la Medicina del Futuro.
SPONSOR:
👉 https://ysioscapital.com/
Invirtiendo en la medicina del futuro desde 2008 💸🧪🔬
Exploramos uno de los temas más relevantes en la farmacología moderna: la obesidad y su tratamiento. Desde los revolucionarios agonistas de GLP-1 hasta la nueva diana terapéutica emergente: la Amilina, analizamos el impacto de estos tratamientos en la salud pública y en el sector farmacéutico. Además, comentamos las dinámicas de mercado, los retos de la producción y las estrategias de innovación que están liderando gigantes como Novo Nordisk, Eli Lilly o Astra Zeneca y compañías al alza como Zealand Pharma.
Temas Tratados:
[0:15]: Obesidad y diabetes: hot topic.
[1:00]: Agonistas de GLP-1 la revolución inesperada
[3:02]: Mortalidad en obesidad: más allá de un tratamiento cosmético.
[4:03]: La obesidad como la gran epidemia del siglo XXI.
[5:30]: Cambios de paradigma en el tratamiento de la obesidad: del estigma a la revolución.
[7:03]: Novo Nordisk: la empresa más valiosa de Europa.
[8:12]: Problemas de tolerancia y adherencia en los tratamientos actuales.
[9:13]: Obesidad como enfermedad crónica: efecto rebote.
[10:17]: Amilina: la nueva diana terapéutica en obesidad.
[12:05]: Diferencias clave entre Amilina y GLP-1: de la falta de apetito a la saciedad.
[15:07]: Estrategias de innovación: combinaciones y nuevos desarrollos de Amilina.
[17:31]: Zealand Pharma: avances clínicos y rondas de financiación en Amilina.
[19:02]: Canibalización interna en farma: estrategias frente al vencimiento de patentes.
[21:13]: Nuevos players en la carrera: Zealand Pharma (de nuevo daneses)
[23:12]: Desafíos en el desarrollo y comercialización de nuevos tratamientos.
SPONSOR:
👉 https://ysioscapital.com/
Invirtiendo en la medicina del futuro desde 2008 💸🧪🔬
Jordi Xiol vivió en Boston como postdoctorado en Harvard durante años.
Hoy, como Venture Capitalist, observa con mucha atención lo que sucederá en las elecciones americanas el próximo 5 de noviembre de 2024.
En este episodio, analizamos a fondo este momento histórico en clave pharma y biotech.
Temas Tratados:
[01:00]: Unas elecciones "once in a lifetime"
[02:00]: El 50% de las ventas globales en medicamentos ocurre en EE. UU.
[05:07]: Comprender la complejidad del sistema sanitario estadounidense
[07:50]: Donald Trump VS Kamala Harris
[17:05]: El poder de negociación de Medicare
[20:06]: ¿El fin de la propiedad intelectual?
[22:05]: Estados bisagra o "swing states"
[26:56]: El juego de los titulares
SPONSOR:
👉 https://ysioscapital.com/
Invirtiendo en la medicina del futuro desde 2008 💸🧪🔬
El Congreso ESMO 2024, celebrado en Barcelona, es uno de los eventos más destacados a nivel global en oncología. Con más de 33.000 asistentes, este congreso se conviertió en el epicentro de la investigación y los avances clínicos en cáncer. En este episodio de Píldoras de Biotech (el primero presencial), exploramos cómo los descubrimientos más recientes están transformando el panorama del tratamiento oncológico. Analizamos el papel emergente de China en los ensayos clínicos de primer nivel, y revisamos los nuevos fármacos que pueden desafiar al gran dominador Keytruda (Pembrolizumab).
Temas Tratados:
[0:25]: Un Venture Capital presente en un Congreso de Oncología.
[1:30]: ESMO en su contexto: el 2º congreso más importante del mundo.
[02:38]: Symposiums presidenciales sin "standing ovations".
[04:10]: Biespecíficos: un avance respecto a los anticuerpos monoclonales.
[05:30]: Ensayos clínicos "Made in China".
[06:20]: Summit Therapeutics: un +270 % en bolsa.
[07:11]: ¿Se puede batir a Keytruda (pembrolizumab)?: el fármaco más vendido del mundo, 27 Bn $.
[09:59]: BioNTech también realiza ensayos en China.
[11:22]: Pfizer aborda la caquexia en pacientes de cáncer.
[13:40]: KRAS: diana terapéutica en boga.
[14:40]: Balance de 10 años de inmunoterapia en oncología.
[15:50]: La evolución profesional dentro de un Venture Capital de Life-Sciences.
SPONSOR:
👉 https://ysioscapital.com/
Invirtiendo en la medicina del futuro desde 2008 💸🧪🔬
Revolution Medicines ha enfrentado uno de los mayores desafíos de la oncología: KRAS, una diana terapéutica considerada como "undruggable" o imposible de atacar.
En este episodio analizamos los resultados de RMC-6236 en Cáncer de Pánceas, como sabes, uno de los más letales. Veremos también que panorama dibuja esto para el entorno competitivo: Mirati, Amgen, Eli Lilly, Pfizer...
Temas Tratados:
[01:01]: Resultados en ensayos clínicos de fase II en Cáncer de Páncreas
[02:00]: El cáncer más letal: 10% de supervivencia a 5 años
[03:01]: La diana terapéutica imposible: KRAS
[06:15]: Arsenal terapéutico en adenocarcinoma de páncreas
[08:01]: 7 Bn € de valoración para Revolution Medicines
[09:30]: Respuesta clínica, 9 meses Supervivencia Libre de Progresión (PFS)
[13:30]: Cómo resolver el rompecabezas de KRAS
[18:26]: 6 años desde la fundación hasta IPO (salida a bolsa)
[21:26]: Pendientes de la fase III: Pfizer, Lilly & Co a la carrera
SPONSOR:
👉 https://ysioscapital.com/
Invirtiendo en la medicina del futuro desde 2008 💸🧪🔬
Los resultados más esperados del año por la comunidad Biotech ya están aquí. La fase III de un ensayo clínico es el momento de la verdad y en este episodio Jordi y Enric nos sumergen en el caso Alnylam.
Temas Tratados:
[01:14]: Los resultados más esperados del año del sector Biotech
[02:32]: 250.000 pacientes en todo el mundo
[03:57]: RNA de interferencia, una tecnología revolucionaria
[05:29]: Crecer un 60% en bolsa en 1 día
[06:28]: Un poema en LinkedIn
[07:49]: De petunia y gusanos a medicina real
[11:30]: ARNm y ARNi, puntos en común
[13:36]: La fiebre del oro en Farma & Biotech
[15:35]: Levantar 4.000 M € en financiación
[16:52]: Nuevas dianas terapéuticas para el ARN de interferencia
[22:10]: En búsqueda del largo plazo
SPONSOR:
👉 https://ysioscapital.com/
Invirtiendo en la medicina del futuro desde 2008 💸🧪🔬
Con Jordi Xiol y Enric Miquel nos sumergimos en el apasionante mundo de la oncología, trayéndote lo más destacado del congreso más importante del año: el ASCO 2024 en Chicago. Este evento reunió a los mejores investigadores y profesionales de la salud para discutir los últimos avances y descubrimientos en el tratamiento del cáncer.
Temas Tratados:
[01:30]: Intro Píldoras de Biotech
[02:43]: El congreso más importante de oncología del mundo
[04:19]: Real Madrid y Astra Zeneca
[06:00]: La plenaria de la American Society of Clinical Oncology (ASCO)
[07:45]: Estudio DESTINY y la quimioterapia dirigida
[09:35]: ENHERTU, una apuesta del Dr. Baselga
[12:54]: Acuerdo de licencia multimillonario: Daiichi Sankyo y AstraZeneca
[14:46]: Polémica en el LAURA Trial
[18:56]: Standing ovation ¿entra tu puntero láser entre 2 curvas?
[21:48]: ¿A qué debemos estar atentos en oncología?
SPONSOR:
👉 https://ysioscapital.com/
Invirtiendo en la medicina del futuro desde 2008 💸🧪🔬